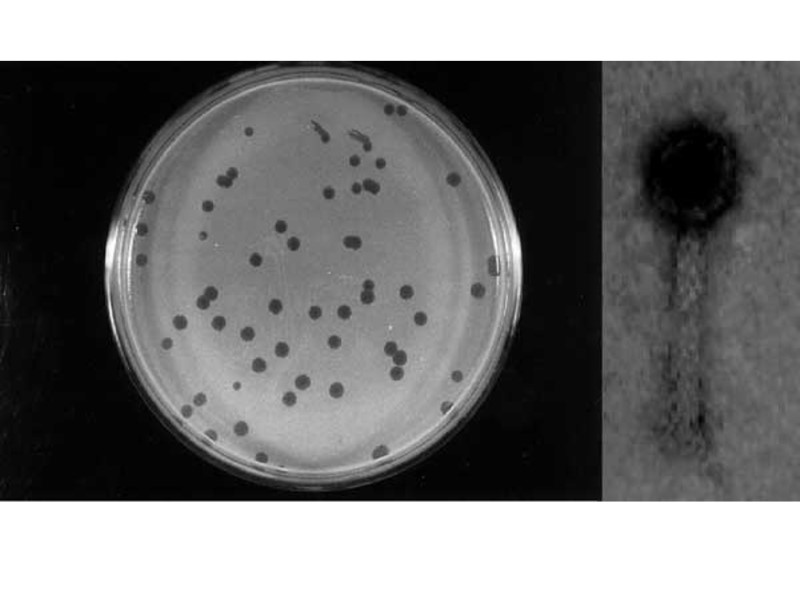
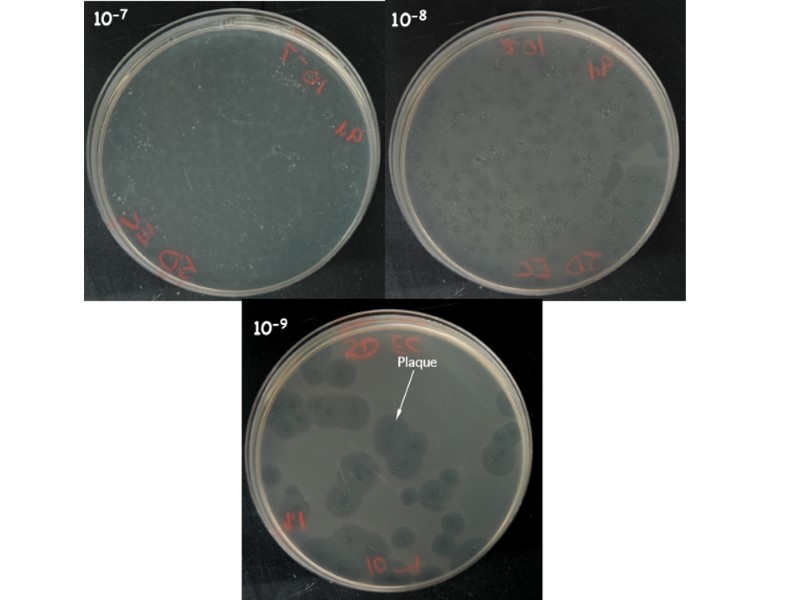

ҚАРАҒАНДЫ МЕМЛЕКЕТТІК МЕДИЦИНА УНИВЕРСИТЕТІ МИКРОБИОЛОГИЯ ЖӘНЕ ИММУНОЛОГИЯ КАФЕДРАСЫ


ҚАРАҒАНДЫ МЕМЛЕКЕТТІК МЕДИЦИНА УНИВЕРСИТЕТІ МИКРОБИОЛОГИЯ ЖӘНЕ ИММУНОЛОГИЯ КАФЕДРАСЫ 5В110200 – ҚОҒАМДЫҚ ДЕНСАУЛЫҚ САҚТАУ МАМАНДЫҒЫ 2 КУРС №5 ДӘРІСТІҢ ТАҚЫРЫБЫ «ЖАЛПЫ ВИРУСОЛОГИЯ. ВИРУСТАРДЫ ЖІКТЕУДІҢ ҚАЗІРГІ ПРИНЦИПТЕРІ. ВИРИОННЫҢ ҚҰРЫЛЫСЫ ЖӘНЕ ХИМИЯЛЫҚ ҚҰРАМЫ. ВИРУСТАРДЫҢ ФИЗИОЛОГИЯСЫ ЖӘНЕ БИОХИМИЯСЫ. ВИРУСТЫҚ ИНФЕКЦИЯЛАРДЫҢ ЛАБОРАТОРЛЫҚ ДИАГНОСТИКАСЫ. БАКТЕРИОФАГТАР.» Карағанды – 2012

ДӘРІСТІҢ МАҚСАТЫ Дәрістің соңында вирустар мен бактериофагтардың құрылысының ерекшеліктерін, жіктеудің қазіргі принциптерін, вирустың жасуша иесімен қарым-қатынас этаптарын, вирустарды дақылдандыру әдістерін, бактериофагтарды тәжірибеде қолданылуын студенттер түсіндіре алуы керек.

Вирустар – жасушасыз тіршілік формасы Вирустар (лат. Virus – у) – жасушалық құрылысы жоқ өте ұсақ микроорганизмдер, эукариоттық және прокариоттық жасушаларға енуге және сонда көбеюге қабілетті. 3 Аденовирус вирионының модельі Темекі теңбілінің вирусы (ТТВ)

Вирустар – жасушасыз тіршілік формасы Барлық вирустар – клетка ішілік паразиттер, бірақ тіршілік белгілерін жасушаға енген соң көрсетеді, сондықтан вирустардың екі түрін ажыратады: 1. Тыныштық күйі (жасушадан тыс орналасқанын - вирион); 2. Вирустардың репродукциялануы (жасушаішілігін - вирус деп атайды). Вирустардың мөлшері 15 -350 нм дейін болады, сондықтан да оларды электронды микроскоптың көмегімен көруге болады. 4

Вирустардың ашылу тарихы 1798 ж. медициналық тәжірибеге Э.Дженнер шешекке қарсы екпені енгізді. 1884 ж. Л.Пастер құтыруға қарсы вакцинаны ашты. 1892 ж. Д.И.Ивановский, темекінің теңбіл ауруын зерттегенде, бактериядан да өте ұсақ организмнің барын айтты. 1899 ж. М.Бейеринк «вирус» терминін енгізді. 1911 ж. Раус тауықтардан қатерлі ісік вирусын ашты. 1915 ж. Ф.Тоурт бактериофагты ашты. 1946 ж. Электронды микроскоптың көмегімен вирустың бөлшектерін (вириондар) көруге және оның құрылысын зерттеуге мүмкіндік туды. 5 Д.И. Ивановский (1864-1920) және Эдуард Дженнер (1749-1823)

ВИРУСТАРДЫҢ НЕГІЗГІ ҚАСИЕТТЕРІ 1. Мөлшері өте ұсақ; 2. Вирионның құрамында нуклеин қышқылының біреуінің ғана болуы (ДНҚ немесе РНҚ); 3. Екі бөлініп (бинарное) өсу қабілеттілігі жоқ, өзінше репродукцияланып дисъюнктивті тәсілмен көбейеді; 4. Құрылысы өте қарапайым, яғни вирион –құрамында ДНҚ немесе РНҚ-дан тұратын геном, капсид (ақуыздық қабат), капсомерлер (ақуыз молекулалары) болады; 5. Жасушалық құрылымы жоқ (цитоплазма, жасушалық мембраналар, рибосомалар т.б. болмайды); 6. Паразитизмнің ерекше сатысына ие: жасушаішілік генетикалық дәрежедегі паразиттер болып саналады.

ВИРУСТАРДЫҢ ЖІКТЕЛУІ Вирустарды жіктеу жүйесі 1966 ж ICTV (International Committee on Taxonomy of Viruses) Вирустар Таксономиясы бойынша Халықаралық комитетте қабылданды. Вирустардың қазіргі заманғы классификациясы негізіне 3 мынадай белгілері жатады: нуклеин қышқылының типі (РНҚ немесе ДНҚ), оның құрылымы тізбекше немесе жіпше саны (бір н/е екі жіпше); сыртқы қабаттың болуы немесе болмауы. Екінші дәрежелі белгілері ескеріледі: жасуша иесінің түрі; капсидтің пішіні; иммунологиялық қасиеттері; ауруды тудыратын вирустың түрі. 7

ВИРУСТАРДЫҢ ЖІКТЕЛУІ Классификация бойынша иерархиялық деңгей қарастырылған: I. Қатар (-virales) II. Тұқымдастық (-viridae) III. Тұқымдастықша(-virinae) IV Туыстастық(-virus) V. Түр (-virus) 8

ВИРИОННЫҢ ҚҰРЫЛЫСЫ Вириондар әр түрлі пішінге ие: сфералы; таяқша тәрізді; кристаллдық және т.б. Вирионның ішінде нуклеин қышқылы болады: (ДНҚ н/е РНҚ), капсид-ақуыздық қабат. 9

ВИРУСТАРДЫҢ ҚҰРЫЛЫСЫ Вирустарды құрылысы бойынша екі топқа бөледі: 10 ВИРУСТАР Қарапайым: ДНҚ н/е РНҚ ж/е бір ақуыздық қабаттан тұрады; мөлшері – 15-150 нм; капсидтері кристалдық ж/е таяқша тәрізді. Күрделі: ДНҚ н/е РНҚ ж/е 2-3 қабаттан тұрады: ақуыздық, липопротеидтік ж/е көмірсутектік; мөлшері– 80-350 нм; капсидтері сфералық.

ВИРУСТАРДЫҢ ҚҰРЫЛЫСЫНЫҢ СХЕМАСЫ

Толығымен қалыптасқан вирустық бөлшек вирион деп аталады. Капсидтер ақуыздық суббірліктерден (капсомерлерден) құрылған. Әрбір капсомер - ақуыздардың бір немесе бірнеше түрлерінен тұратын тиісті молекулалық салмағы (массасы) бар ақуыз молекуласы. Капсомерлердің кеңістіктегі орнына сәйкес капсид симметриясының екі түрі болады: 1. Шиыршық (спираль) (таяқша, жіпше тәрізді: өсімдіктің вирустары). 2. Кубтық (икосаэдр пішінді: жануар және адам вирустары, бактерия вирустарында – бактериофагтарда бактериофагтар). 12

13 Вирустардың әр түрлі пішіні және мөлшері: а – өсімдік вирустары; б – жануар ж/е адам вирустары; в –бактериофагтар. а б в

ВИРУСТАРДЫҢ РЕПРОДУКЦИЯСЫ 14

ВИРУСТАРДЫҢ РЕПРОДУКЦИЯСЫ Вирустардың қалыптасуы иесінің жасушасында жүреді және бірнеше сатылардан тұрады: 1. жасушаға жабысу (адсорбция); 2. вирустың жасушаға енуі; 3. вирустардың шешінуі; 4. вирус ақуыздары мен ферменттерінің синтезі; 5. вириондардың жиналуы. 6. зақымданған жасушадан вириондардың шығуы және жаңа жасушаларды жұқтыру. 15

ВИРУСТАР АЛУАН ТҮРЛІ 16 2-сурет. Темекі теңбілінің вирионы. 1-сурет. Герпес вирусының вирионы Вирустардың 1000 түрі белгілі 4-сурет. Аденовирус вирионы 3-сурет. Адамның иммунитет тапшылық вирусы

АДАМНЫҢ ВИРУСТЫҚ АУРУЛАРЫ 17

ВИРУСТАРДЫ ДАҚЫЛДАНДЫРУ 18 1-сур. Бауыр жасушасында (13) герпес вирусының қірінділері (12) 2-сур. Тауық эмбрионын жұқтыру тәсілі (1-амнионға, 2-аллантоисқа, 3-сарыуыздық қап)

БАКТЕРИОФАГТАР

Фагтар физиологиясы мен морфологиясына қарай 5 топқа жіктеледі: I топ – жіпше тәрізді фагтар – ақуызды түтікше, құрамында бір нуклеин қышқылы болады; II топ – басының пішіні икосаедр түріндегі өсінді аналогы бар фагтар, құрамында бактериалдық жасушаға бекіну үшін ДНҚ немесе РНҚ болады; ІІІ топ – құрамында қос тізбекті ДНҚ мен қысқа өсіндісі болатын көпқырлы ақуызды фагтар. IV топ – қос тізбекті ДНҚ молекуласы, ұзын өсіндісі қысқарылмайтын көпқырлы фагтар; V топ – жабыны жиырылуға қабілетті, күрделі өсіндісі бар фагтар.

I топ – жіпше тәрізді фагтар – ақуызды түтікше, құрамында бір нуклеин қышқылы болады; Бір тізбекті ДНҚ

II топ – басының пішіні икосаедр түріндегі өсінді аналогы бар фагтар, құрамында бактериалдық жасушаға бекіну үшін ДНҚ немесе РНҚ болады; Бір тізбекті РНҚ және ДНҚ

ІІІ топ – құрамында қос тізбекті ДНҚ мен қысқа өсіндісі болатын көпқырлы ақуызды фагтар. Қос тізбекті ДНҚ

IV топ – қос тізбекті ДНҚ молекуласы, ұзын өсіндісі қысқартылмайтын көпқырлы фагтар; Қос тізбекті ДНҚ

V топ – жабыны жиырылуға қабілетті, күрделі өсіндісі бар фагтар. Қос тізбекті ДНҚ



ӘСЕР ЕТУ СПЕКТРІ БОЙЫНША БАКТЕРИОФАГТАРДЫҢ ЖІКТЕЛУІ полифагтар бактерияның туыстас түрлерімен әрекеттесетін түрі (сальмонеллезді бактериофаг). монофагтар бактериялардың белгілі бір түрімен әрекеттесетін түрі (тырысқақ монофагы). типтік фагтар берілген түрдің бір ғана типімен (варианттарымен) әрекеттесетін түрі (фаговар)

Бактерия жасушасына әсер ету нәтижесіне байланысты фагтардың жіктелуі вирулентті фаг лизис вирулентті фаг дефектілі фаг жалпы абортивті трансдукция

Бактерия жасушасына әсер ету нәтижесіне байланысты фагтардың жіктелуі Әлсіз фаг лизогения бактериялардың фенотипі өзгермейді бактерияның фенотипі өзгеруімен (фагтың конверсиясы) лизис әлсіз дефектілі арнайы трансдукция

Фаг пен жасушаның өзара байланысының кезеңдері: 1 кезең – бактериалды жасушаның беткейіне фагтың өсіндісінің ұшындағы жіпшелерінің көмегімен адсорбциясы. Бір бактериалды жасушаға 300-ге дейін фагты бөлшек бекітілуі мүмкін. 2 кезең – жасушаға ДНҚ енуі, өсінді жабыны жиырылады, өсінді қабықшаны тескеннен кейін жасуша қабықшасында канал пайда болады, ол арқылы бактериофаг өзінің ДНҚ-сын жасуша ішіне енгізеді, фагтың өзі жасушаның сыртында қалады. Осындай НҚ вегетативті фаг деп аталады. 3 кезең – латентті, осы кезеңде ақуыздар мен НҚ синтезі жүреді, ақпараттық ДНҚ пайда болады, бактериалды жасушаның рибосомасына тасымалданады, онда ферменттердің синтезі жүреді. 4 кезең – фагты бөлшектердің жиналуы, өсіндіде ақуыздар геометриялық тәртіппен жинақталып басты құрайды да басы НҚ толады. 5 кезең – фагтардың жасушадан шығуы, бактериалды қабықша ішкі жағынан қысқарып лизиске ұшырайды, нәтижесінде қабықша жарылып фагтар жасушадан кенет бір мезгілде шығады да, фагтар жан-жаққа тарап кетеді.

СЕЗІМТАЛ ЖАСУШАМЕН ВИРУЛЕНТТІ ЖӘНЕ ӘЛСІЗ БАКТЕРИОФАГТАРДЫҢ ӨЗАРА БАЙЛАНЫСЫ А – фагтың жасушаға жабысуы; Б – бактерия хромосомасына ДНҚ фагтың интеграциясы; В – ДНҚ фаг. бактер. репликациясы; Г – жасушаның бөлінуі; Д –ДНҚ фагтың репликациясы ж/е фаг. ақуыз. синтезі; Е – капсидтердің құрылуы; Ж – ДНҚ-ң капсидтерде жиналуы; З – фаг. бөлікт.; И – жасуш. лизис. ж/е фаг бөліктер. шығуы.

БАКТЕРИОФАГТАРДЫ ТӘЖІРИБЕДЕ ҚОЛДАНУ Фагодиагностика Патологиялық материалдан бактерия түрін бөліп алу Фагты сүзгіден өткізу реакциясы Таза дақылды идентификациялау түрді анықтау фагоиндикация фаговарды анықтау фаготиптеу

БАКТЕРИОФАГТАРДЫ ТӘЖІРИБЕДЕ ҚОЛДАНУ Фаготерапия Фаг жергілікті қолданылады Фагопрофилактика Іш сүзегі дизентерия

БАКТЕРИОФАГТЫ БӨЛІП АЛУ материал сыртқы ортаның объектісі бактерия дақылы бактериалды сүзгі (фильтр) фильтрат ЕПС + сезімтал бактерия инкубация Өсу жоқ – фаг болады (сүзгі арқылы тазартады) Өсу бар – фаг болмайды

ФАГОИНДИКАЦИЯ ӘДІСІ «АҒЫП ЖИНАЛҒАН ТАМШЫ» ортаға дақылдың тамшысын жағады тамшының ағу жолы бойынша жасушаларды тіркейді өсу бар – - өсу жоқ – +



АППЕЛЬМАН Б/ША ФАГТЫ ТИТРЛЕУ ӘДІСІ

ГРАЦИА Б/ША ФАГТЫ ТИТРЛЕУ ӘДІСІ ЕПА + құрамында фаг бар материалды сұйылту + сезімтал дақыл ЕПА ортасы бар Петри табақшасы (кесілген)

БАКТЕРИЯЛАРДЫ ФАГОТИПТЕУ Зерттелетін штаммды пластинка тәрізді агарға газон әдісімен егу. әр түрлі типоспецификалық фаг тамшысын тамызады. инкубация “стерильді дақтарды” («бляшека») тіркеу фаготип (фаговар) = лизисін туғызған типтік фагтың тізімі.


НАЗАР АУДАРҒАНДАРЫҢЫЗҒА РАХМЕТ!!!
19920-7_virus.ppt
- Количество слайдов: 45

